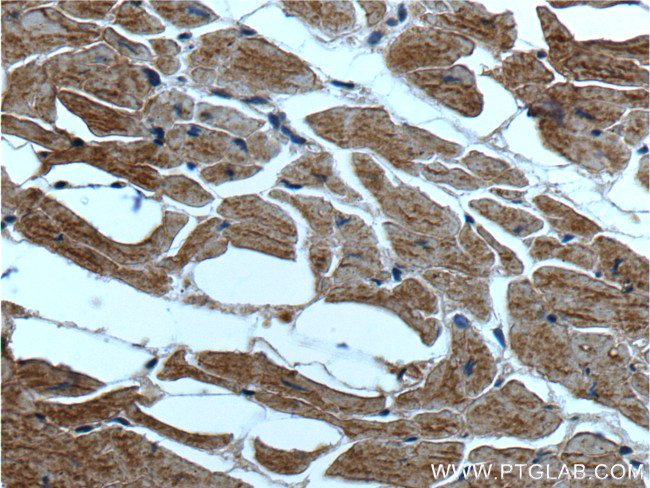
ST2 Antibody in Immunohistochemistry (Paraffin) (IHC (P))

Search
Proteintech
ST2 Monoclonal Antibody (7A2A7)
{{$productOrderCtrl.translations['antibody.pdp.commerceCard.promotion.promotions']}}
{{$productOrderCtrl.translations['antibody.pdp.commerceCard.promotion.viewpromo']}}
{{$productOrderCtrl.translations['antibody.pdp.commerceCard.promotion.promocode']}}: {{promo.promoCode}} {{promo.promoTitle}} {{promo.promoDescription}}. {{$productOrderCtrl.translations['antibody.pdp.commerceCard.promotion.learnmore']}}
产品信息
60112-1-IG
种属反应
宿主/亚型
分类
类型
克隆号
抗原
偶联物
形式
浓度
规格
纯化类型
保存液
内含物
保存条件
运输条件
产品详细信息
Immunogen sequence: WILAILTIL MYSTAAKFSK QSWGLENEAL IVRCPRQGKP SYTVDWYYSQ TNKSIPTQER NRVFASGQLL KFLPAAVADS GIYTCIVRSP TFNRTGYANV TIYKKQSDCN VPDYLMYSTV SGSEKNSKIY CPTIDLYNWT APLEWFKNCQ ALQGSRYRAH KSFLVIDNVM TEDAGDYTCK FIHNENGANY SVTATRSFTV KDEQGFSLFP VIGAPAQNEI KEVEIGKNAN LTCSACFGKG TQFLAAVLWQ LNGTKITDFG EPRIQQEEGQ NQSFSNGLAC LDMVLRIADV KEEDLLLQYD CLALNLHGLR RHTVRLSRKN PSKECF (4-328 aa encoded by B C030975)
靶标信息
IL-33R, also known as ST2, is a receptor for IL-33. It is a member of the IL-1 receptor family of innate receptors. Its extracellular domain consists of 3 Ig-like domains that directly interact with its co-receptor IL-1RAcP, and the ligand alarmin, IL-33. IL-33 ligation results in the association of IL-33R complex with its adaptor proteins MyD88, IRAK1, IRAK4 and TRAF6, and activation of the NF-kB, and MAPK pathways. This, in turn, instigates the release of chemokines and cytokines such as IL-5, IL-6, IL-8, and IL-13. Two most common isoforms of IL-33R that result from alternative splicing are ST2L - the membrane bound form, and ST2S - the soluble form. The membrane bound form can be released from the cell surface by proteolytic cleavage. The soluble forms have been suggested to act as decoys dampening the IL-33 signaling. IL-33R is primarily expressed by mast cells, basophils, and eosinophils. In mouse, IL-33R expression has been shown on ILC2 and Th2 cells. IL-33R signaling has been implicated in the number of immune conditions, including allergies, arthritis, atherosclerosis and sepsis.
仅用于科研。不用于诊断过程。未经明确授权不得转售。
生物信息学
蛋白别名: Fit-1; Fos-responsive gene 1 protein; growth stimulation-expressed; homolog of mouse growth stimulation-expressed; IL-1 R4; IL-1RL1; IL-33R; interleukin 1 receptor-related protein; Interleukin-1 receptor-like 1; Interleukin-33 receptor alpha chain; Interleukin1 receptor like 1; Lymphocyte antigen 84; Protein ST2; Protein T1; sIL 33R; soluble IL 33 Receptor; soluble IL 33R; soluble protein receptor; unnamed protein product
基因别名: DER4; FIT-1; FIT1; IL1RL1; IL33R; Ly84; ST2; St2-rs1; ST2L; ST2V; Ste2; T1; T1/ST2
UniProt ID: (Human) Q01638, (Mouse) P14719, (Rat) Q62611
Entrez Gene ID: (Human) 9173, (Pig) 100127134, (Mouse) 17082, (Rat) 25556